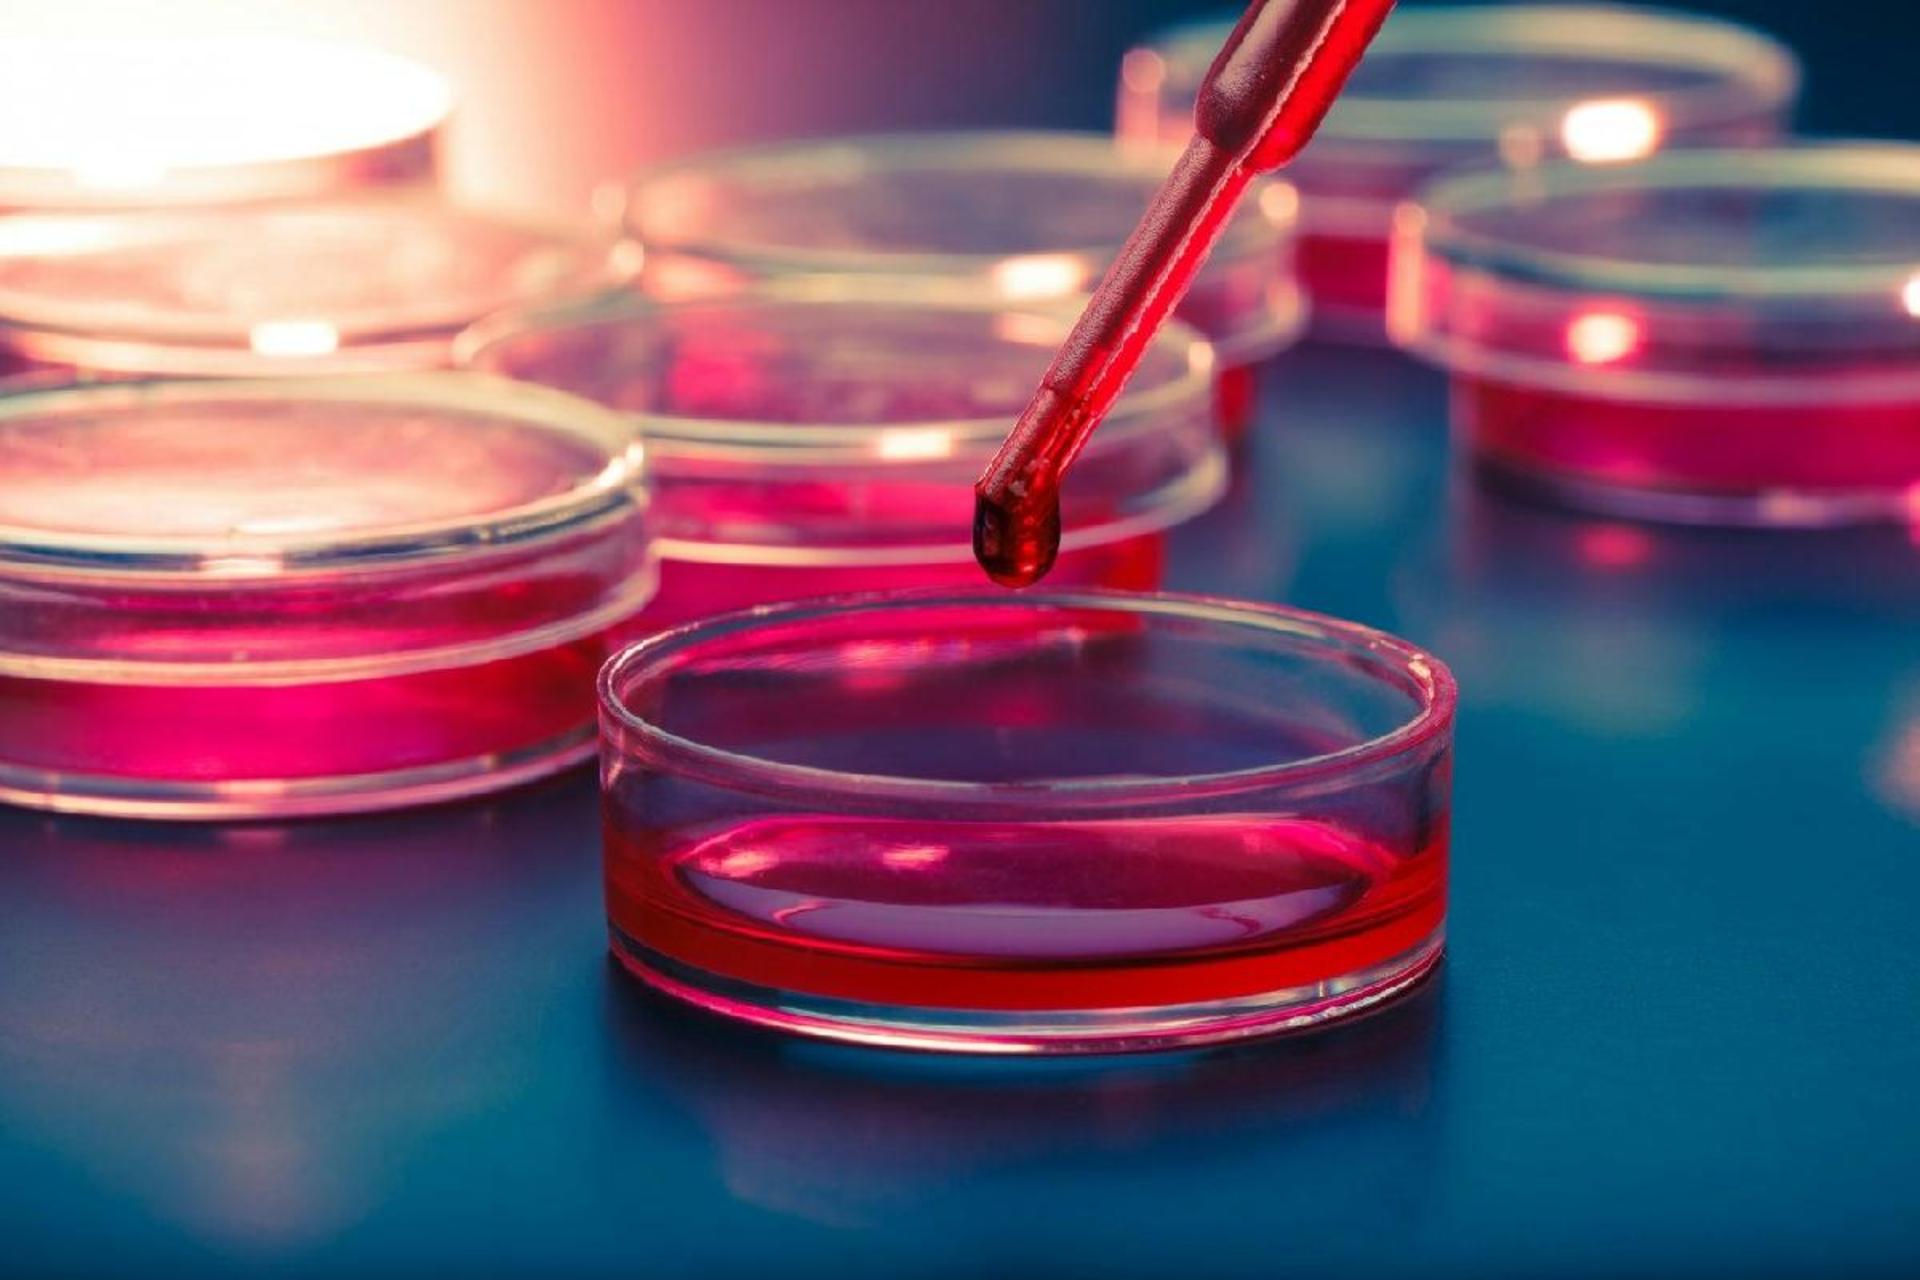
سلول‌های بنیادی نقص مادرزادی قلب یک نوزاد را درمان کردند

مرد مبتلا به نارسایی قلبی با دریافت قلب تیتانیومی توانست زنده بماند

مردی ۵۸ ساله در ایالات متحده اولین فرد در جهان است که قلبش را با دستگاه پمپ خون موقت تیتانیومی جایگزین کرده است. این فرد مبتلا به نارسایی قلبی مرحلهی آخر بوده است.
قلب فلزی که به نظر میرسد برای ربات ساخته شده، در واقع توسط شرکت تجهیزات پزشکی بیواکور (BiVACOR) طراحی شده است. این قلب تیتانیومی قرار است تا زمانی که قلب اهدایی مناسب برای پیوند در دسترس قرار گیرد، جایگزین عملکرد کامل قلب انسان شود.
قلب مصنوعی کامل (TAH) برای تپیدن مانند قلب واقعی طراحی نشده است؛ اما بیواکور ادعا میکند که قلب فلزیاش حتی بدون محفظههای انعطافپذیر یا دیافراگمهای پمپاژ، به اندازهی کافی قدرتمند است تا از گیرندهی خود درحین ورزش حمایت کند و به اندازهی کافی کوچک است تا برای اکثر مردان و زنان مناسب باشد.
قلب مصنوعی دستگاهی با محفظهی دوگانه به اندازهی یک مشت، عملا نشکن و مقاوم دربرابر خوردگی و سایش است. تنها بخش متحرک، درون آن پنهان است: یک روتور معلق مغناطیسی که خون را به ریهها پمپاژ میکند. از آنجایی که روتور چرخان با هیچ سطح دیگری تماس پیدا نمیکند، احتمال آسیبدیدگی آن به مرور زمان دراثر اصطکاک صفر است.
تنظیمات قلب تیتانیومی از جریان مداوم به تپنده قابل تغییر است
کل دستگاه توسط یک کنترلر کوچک و خارجی تغذیه میشود که قابلحمل است و از طریق معده از بدن خارج میشود.
ده سال زمان برای بررسی طراحیهای متعدد و آزمایشهای گسترده روی حیوانات نیاز بود تا قلب مصنوعی بیواکور سرانجام بتواند به قفسهی سینه یک بیمار زندهی مبتلا به نارسایی قلبیِ مرحلهی آخر راه یابد. این عمل جراحی در مرکز پزشکی بیلور سنت لوک در موسسهی قلب تگزاس انجام شد و بهطرز چشمگیر، هیچ عارضهای را به دنبال نداشت.
به گفتهی پزشکان بیمار، قلب تیتانیومی به مدت هشت روز بهطور موثر عمل کرد و زندگی بیمار را تا زمانی که قلب اهداکنندهی مناسب در دسترس قرار گرفت، حفظ کرد.
دانیل تیمز، بنیانگذار بیواکور، میگوید: «بسیار مفتخرم که شاهد کاشت موفقیتآمیز قلب مصنوعی کامل خودمان برای اولین بار در انسان هستم. این دستاورد بدون شجاعت اولین بیمار ما و خانوادهاش، فداکاری تیم ما و همکاران متخصص ما در موسسهی قلب تگزاس محقق نمیشد.»
امروزه موثرترین درمان برای افراد مبتلا به نارسایی شدید قلبی، قلب اهداکنندهی واقعی است، اما این قلب همیشه به موقع در دسترس نیست. در سطح جهان، سالانه کمتر از ۶هزار پیوند قلب انجام میشود.
قلبهای مصنوعی نقش مهمی در افزایش و بهبود کیفیت زندگی بیماران واجد شرایط پیوند دارند. آنها راه نجاتی را برای کسانی که در معرض خطر مرگ قریبالوقوع هستند در حالی که منتظر قلب اهدایی هستند، فراهم میکنند.
با این حال، در طول دو دههی گذشته، تنها یک قلب مصنوعی از سازمان غذا و داروی ایالات متحده (FDA) تاییدیهی تجاری دریافت کرده است. این دستگاه که «قلب مصنوعی کامل سینکاردیا» نام دارد، دارای غشاها و دریچههای انعطافپذیر بسیار بزرگ است و برای مدت زمان طولانی درون بدن دوام خاصی ندارد.

قلب سینکاردیا در سال ۲۰۰۴ توسط FDA تایید شد و در بیش از ۱٬۴۰۰ بیمار کاشته شد و حتی به آنها اجازه داد تا زمانی که منتظر قلب اهداکننده هستند به خانه بروند.
با این حال، ۱۲ درصد از بیماران گیرندهی قلب سینکاردیا دچار سکتهی مغزی شدند و ۱۴ درصد حوادث ترومبوز (لخته در عروق که مانع جریان خون است) را تجربه کردند. انتظار میرود طرح بیواکور این خطرات را کاهش دهد.
سینکاردیا همچنین در مقایسه با بیواکور که شبیه قلب انسان است، بسیار بزرگ است و از موادی ساخته شده که دوام کمتری دارند. بیواکور از تیتانیوم ساخته شده است که در حال حاضر معمولا برای ایمپلنتهای ارتوپدی استفاده میشود. تیتانیوم به راحتی اکسید میشود و یک لایهی بیولوژیکی خنثی ایجاد میکند که دستگاه را میپوشاند و از آن در برابر هرگونه واکنش بیولوژیکی بدن محافظت میکند.
قلب بیواکور به عنوان پیشرفتی پیشگامانه، از نگاه سازندگانش یک «جابهجایی پارادایم» در طراحی قلب مصنوعی با ماندگاری بالا، توصیف میشود. بااینحال، هیچکس هنوز نمیداند که قلب بیواکور چه مدت در انسان کار میکند. این دستگاه در آزمونهای آزمایشگاهی، به طور مداوم به مدت چهار سال بدون هیچ مشکلی به طور روان و پیوسته کار کرده است.
قلب مصنوعی راهی حیاتی برای افزایش و بهبود کیفیت زندگی بیماران واجد شرایط پیوند در معرض خطر مرگ قریب الوقوع است
قلب مصنوعی سینکاردیا نیز که فقط برای کوتاه مدت طراحی شده، سالها در برخی از بیمارانی که منتظر دریافت پیوند هستند، دوام آورده است.
در نوامبر سال گذشته، بیواکور مجوز FDA را برای کاشت قلب مصنوعی کامل خود در پنج بیمار مبتلا به نارسایی قلبی مرحلهی پایانی در سال ۲۰۲۴ دریافت کرد. با توجه به موفقیت اولین ایمپلنت، انتظار میرود پیوندهای بیشتری در آینده نزدیک انجام شود.